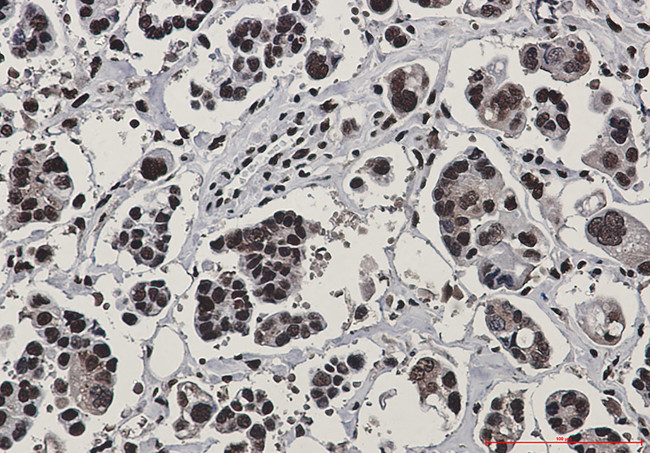
RAD50 Antibody in Immunohistochemistry (Paraffin) (IHC (P))

Search
Invitrogen
RAD50 Recombinant Rabbit Monoclonal Antibody (K01_2P20)
{{$productOrderCtrl.translations['antibody.pdp.commerceCard.promotion.promotions']}}
{{$productOrderCtrl.translations['antibody.pdp.commerceCard.promotion.viewpromo']}}
{{$productOrderCtrl.translations['antibody.pdp.commerceCard.promotion.promocode']}}: {{promo.promoCode}} {{promo.promoTitle}} {{promo.promoDescription}}. {{$productOrderCtrl.translations['antibody.pdp.commerceCard.promotion.learnmore']}}
图: 1 / 2
RAD50 Antibody (MA564185) in IHC (P)


产品信息
MA564185
种属反应
宿主/亚型
Expression System
分类
类型
克隆号
抗原
偶联物
形式
浓度
规格
纯化类型
保存液
内含物
保存条件
运输条件
RRID
产品详细信息
Immunogen sequence: MSRIEKMSIL GVRSFGIEDK DKQIITFFSP LTILVGPNGA GKTTIIECLK YICTGDFPPG TKGNTFVHDP KVAQETDVRA QIRLQFRDVN GELIAVQRSM VCTQKSKKTE FKTLEGVITR TKHGEKVSLS SKCAEIDREM ISSLGVSKAV LNNVIFCHQE DSNWPLSEGK ALKQKFDEIF SATRYIKALE TLRQVRQTQG QKVKEYQMEL KYLKQYKEKA CEIRDQITSK EAQLTSSKEI VKSYENELDP LKNRLKEIEH NLSKIMKLDN EIKALDSRKK QMEKDNSELE EKMEKVFQGT DEQLNDLYHN HQRTVREKER KLVDCHRELE KLNKESRLLN QEKSELLVEQ GRLQLQADRH QEHIRARDSL IQSLATQLEL DGFERGPFSE RQIKNFHKLV RERQEGEAKT ANQLMNDFAE KETLK
Highest antigen sequence identity to the following orthologs: Mouse - 92%, Rat - 91%, Pig - 95%, Cynomolgus monkey - 100%.
靶标信息
Rad50-13B3 recognizes human Rad50, a 153a protein involved in DNA double strand break repair. Rad50 is associated with Mre11 and p95 (Nibrin) to form a multiprotein complex involved in the double strand break repair process. Upon DNA damage, Rad50 and Mre11 redistribute and are co-localized within the nucleus of damaged cells.
仅用于科研。不用于诊断过程。未经明确授权不得转售。
篇参考文献 (0)
生物信息学
蛋白别名: DNA repair protein RAD50; hRAD50; hsRAD50; RAD50 2; RAD50 homolog, double strand break repair protein; RAD50 PEN; RAD50-2; RAD50-3; unnamed protein product
基因别名: hRad50; NBSLD; RAD50; RAD502
UniProt ID: (Human) Q92878
Entrez Gene ID: (Human) 10111